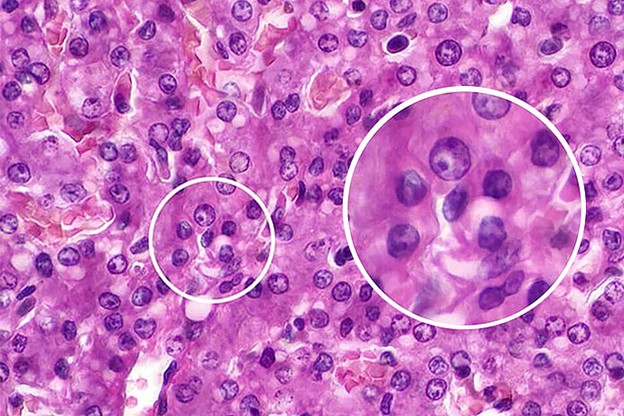
морфология клеток

Статьи — Legion Box
Мониторы Reshin для цифровых патологоанатомических изображений
Патологоанатомы часами изучают препараты, где важна каждая деталь. Цифровизация упростила оценку мельчайших клеточных и тканевых структур, которые теперь переносятся на экраны с помощью высококачественных оптоэлектронных микроскопов, где их можно рассмотреть в мельчайших подробностях. Эта технология упрощает анализ, совместную работу и архивацию данных. Однако она также предъявляет высокие требования к дисплеям, используемым для просмотра. Монитор потребительского уровня просто не рассчитан на точность и точность, необходимые для постановки диагноза по цифровому изображению. Некачественное изображение может привести к перенапряжению глаз и диагностическим ошибкам, поэтому мониторы должны обеспечивать превосходное качество изображения, чтобы можно было обнаружить даже самые незначительные изменения или аномалии.
Компания Reshin предлагает специализированную линейку диагностических мониторов, идеально подходящих для индивидуальных потребностей цифровой патологии. В их число входят MD32C (3 МП), MD50C (5 МП) и первоклассный монитор MD120C (12 МП). Каждый из них обладает не только обладает превосходным разрешением экрана, но и обеспечивают исключительную точность цветопередачи. Высокое (пространственное) разрешение, широкий цветовой охват, глубокий уровень чёрного, равномерная подсветка, калибровочная кривая воспроизведения в соответствии с индивидуальными требованиями и стабильное качество изображения позволяют чётко воспроизводить даже мельчайшие структуры тканей.
Параметры, которые необходимо учитывать при выборе монитора для патологоанатомического исследования
Цифровая патология требует исключительной чёткости для постоянного масштабирования и панорамного просмотра больших объёмов цифровых изображений, с размером файлов в несколько гигабайт. Врач должен исследовать этот огромный цифровой массив, плавно перемещаясь по изображению с возможностью масштабирование от общей картины до просмотра отдельных клеток в режиме высокой детализации. Этот рабочий процесс предъявляет несколько специфических визуальных требований:
- монитор должен иметь быстрое время отклика пикселей, чтобы предотвратить размытость или двоение при движении, когда патолог перемещается по изображению, что может дезориентировать и скрыть тонкие детали.
- яркость и цвет дисплея должны быть идеально равномерными по всему экрану. Любые горячие точки или тусклые углы могут привести к неправильной интерпретации ткани, просматриваемой в этой области.
- монитор должен обеспечивать визуальный комфорт при длительной работе, поскольку патологи проводят за монитором много часов в день. Это обеспечивается подсветка без мерцания и эффективным антибликовым покрытием, необходимы для снижения нагрузки и усталости глаз.
Разрешение
Чем выше разрешение монитора, тем больше деталей видит пользователь. Изображения менее пикселизированы, имеют более чёткие контуры, и больше контента отображается одновременно. Для цифровой патологии рекомендуется минимальное разрешение 4 МП (2560×1440). Для первичной диагностики или сложных случаев лучше всего подходят дисплеи с разрешением 5–8 МП, поскольку они отображают больше деталей одновременно, снижая необходимость в чрезмерном масштабировании и повышая скорость и достоверность диагностики. Это существенное преимущество для рабочего процесса.Вместо того, чтобы постоянно увеличивать масштаб для определения клеточных структур, а затем уменьшать его для просмотра их контекста, монитор с высоким разрешением позволяет пользователю видеть и то, и другое одновременно. Например, на дисплее с разрешением 8 МП патолог может оценить общую архитектуру ткани, сохраняя при этом возможность различать ядерную морфологию отдельных клеток
Диагональ экрана
Для приложений цифровой патологии рекомендуются широкоэкранные мониторы с диагональю от 27 до 32 дюймов, чтобы заполнить естественное поле зрения пользователя.
Такой формат просмотра позволяет патологу лучше видеть взаимосвязь между различными тканевыми структурами без необходимости постоянного перемещения и помогает быстро определять интересующие области для более детального изучения. Однако большой экран эффективен только при высоком разрешении, что позволяет отобразить максимально четкую детализированную картину, больше похожую на изображение микроскопа. Это позволяет патологу быстро менять его масштабирование для определения области скопления аномальных клеток.

Цветовая передача
Медицинский монитор для патологоанатомических исследований должен обладать широким цветовым охватом диапазона не менее 100% пространства sRGB, чтобы отобразить весь спектр цветов, присутствующих в красителях. Он также должен поддерживать цветопередачу от порядка 16,7 миллиона цветов (для 8-битного LUT монитора), более миллиарда цветов (для 10-битного LUT монитора) и выше. Такое значительное увеличение позволяет дисплею отображать тончайшие градиенты и оттенки изображения ткани, которые могут указывать на клеточные аномалии. Патологоанатомическая практика использует для выявления аномальных зон специализированный гистологический краситель - гематоксилин-эозин. Его применение позволяет подкрашивать в определённые цвета компоненты клетки: ядро – синим, а цитоплазму – розовым. Точный оттенок, насыщенность и интенсивность этих цветов дают важнейшую информацию о здоровье и состоянии ткани. Неправильная интерпретация тонких оттенков пятна может привести к неверному выводу.
Широкий цветовой охват и 10-битная глубина цвета позволяют выявить едва заметные вариации оттенка и насыщенности, которые часто имеют диагностическое значение.

Контраст
Для обеспечения высокой дифференциации темных и светлых участков изображения, а также возможности контроля однородности для монитора, используемого в диагностике патологий, рекомендуется коэффициент контрастности не менее 1000:1 (статический коэффициент контрастности).
Однородность
Большое значение также оказывает однородность отображения информации на всей площади экрана монитора. Иначе изображение будет выглядеть по-разному в зависимости от его положения на экране. Это может привести к тому, что пользователю придётся перемещать изображение на мониторе, чтобы получить всю достоверную информацию. Мониторы должны быть оснащены антибликовым покрытием для минимизации отвлекающих отражений, а также технологиями подавления мерцания и низкого уровня синего света для снижения нагрузки на глаза во время длительных сеансов просмотра.

